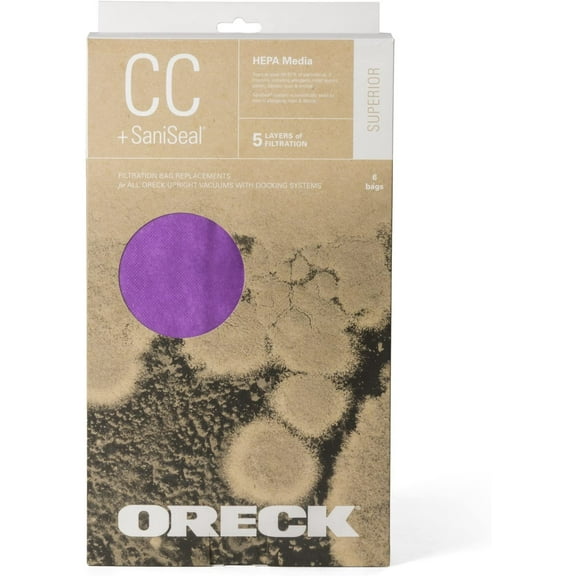
Compatible with Oreck Type CC HEPA Upright Vacuum Cleaner Bag, AK1CC6H, 6-Pack, 6 Pack, Purple, 6 Count

Hoover "A" Replacement Bags
Key item features
- Allergen Filtration: Traps 100% of dust mites and their eggs, and retains 99.9% of ragweed and common grass pollens.
- Particle Capture: Filters a wide range of airborne particles including various pollens, cat dander, spores, and other allergens.
- Enhanced Filtration: Features an electrostatically charged liner that enhances the capture of fine particles.
- Allergy Relief: Ideal for individuals experiencing allergic or dust-related discomforts.
- Broad Compatibility: Fits top-fill upright vacuum cleaners including Convertible, Elite, Legacy, Decades, Concept One, Encore, Power Max, Runabout, Spectrum, Spirit, Sprint, Tempo, and Conquest models.
- Innovation Fit: Also compatible with Innovation Cleaners.
Specs
- CompatibilityFor Hoover
- BrandHoover
- FeaturesAllergen Reducer
- Count per pack12
- Free shipping
Free 30-day returns
How do you want your item?
Compare with similar items
| Product | Viewing this itemHoover "A" Replacement Bags  $13.89 current price $13.89304.6 out of 5 Stars. 30 reviews | Hoover 4010001A Type A Vacuum Bags, 6 Bags  $13.95 current price $13.95944.4 out of 5 Stars. 94 reviews | Hoover 4010001A Type A Vacuum Bags, 9 Bags  Now $13.49 current price Now $13.49, Was $15.40$15.40 394.1 out of 5 Stars. 39 reviews | 10 Pack Hoover Type A Paper Vacuum Bags. Fits Hoover Style A. Replaces Part #4010001A. 2 Ply Micro Filtration  $14.95 current price $14.95185 out of 5 Stars. 18 reviews | Hoover Type A Vacuum Bags (3-Pack), 4010001A  $9.95 current price $9.95674.5 out of 5 Stars. 67 reviews | Hoover Vacuum Bags R30 Microfiltration After Market  Now $5.87 current price Now $5.87, Was $12.15$12.15 | Replacement Part For Hoover Type A Allergen Bag - 3 pack, 4010100A  $11.93 current price $11.9334.3 out of 5 Stars. 3 reviews | Replacement Part For Hoover Vacuum Bags Style K # 4010028K  Now $3.87 current price Now $3.87, Was $9.16$9.16 54.8 out of 5 Stars. 5 reviews | Replacement Part For Hoover 4010001A Type A Vacuum Bags, 3 Bags  $9.56 current price $9.5624.5 out of 5 Stars. 2 reviews | Hoover Type Y Allergen Bags, for WindTunnel Vacuum Cleaners, 3-Pack, 4010100Y, White  $14.93 current price $14.93254.8 out of 5 Stars. 25 reviews |
|---|
| Compatibility | For HooverHoover "A" Replacement Bags | HooverHoover 4010001A Type A Vacuum Bags, 6 Bags | HooverHoover 4010001A Type A Vacuum Bags, 9 Bags | Hoover10 Pack Hoover Type A Paper Vacuum Bags. Fits Hoover Style A. Replaces Part #4010001A. 2 Ply Micro Filtration | HooverHoover Type A Vacuum Bags (3-Pack), 4010001A | HooverHoover Vacuum Bags R30 Microfiltration After Market | HooverReplacement Part For Hoover Type A Allergen Bag - 3 pack, 4010100A | HooverReplacement Part For Hoover Vacuum Bags Style K # 4010028K | HooverReplacement Part For Hoover 4010001A Type A Vacuum Bags, 3 Bags | HooverHoover Type Y Allergen Bags, for WindTunnel Vacuum Cleaners, 3-Pack, 4010100Y, White |
|---|---|---|---|---|---|---|---|---|---|---|
| Features | Allergen ReducerHoover "A" Replacement Bags | Allergen ReducerHoover 4010001A Type A Vacuum Bags, 6 Bags | -Hoover 4010001A Type A Vacuum Bags, 9 Bags | -10 Pack Hoover Type A Paper Vacuum Bags. Fits Hoover Style A. Replaces Part #4010001A. 2 Ply Micro Filtration | -Hoover Type A Vacuum Bags (3-Pack), 4010001A | -Hoover Vacuum Bags R30 Microfiltration After Market | Allergen ReducerReplacement Part For Hoover Type A Allergen Bag - 3 pack, 4010100A | HEPA FiltrationReplacement Part For Hoover Vacuum Bags Style K # 4010028K | -Replacement Part For Hoover 4010001A Type A Vacuum Bags, 3 Bags | Allergen ReducerHoover Type Y Allergen Bags, for WindTunnel Vacuum Cleaners, 3-Pack, 4010100Y, White |
| Count per pack | 12Hoover "A" Replacement Bags | 6Hoover 4010001A Type A Vacuum Bags, 6 Bags | 9Hoover 4010001A Type A Vacuum Bags, 9 Bags | 1010 Pack Hoover Type A Paper Vacuum Bags. Fits Hoover Style A. Replaces Part #4010001A. 2 Ply Micro Filtration | 1Hoover Type A Vacuum Bags (3-Pack), 4010001A | 5Hoover Vacuum Bags R30 Microfiltration After Market | -Replacement Part For Hoover Type A Allergen Bag - 3 pack, 4010100A | 3Replacement Part For Hoover Vacuum Bags Style K # 4010028K | 1Replacement Part For Hoover 4010001A Type A Vacuum Bags, 3 Bags | 3Hoover Type Y Allergen Bags, for WindTunnel Vacuum Cleaners, 3-Pack, 4010100Y, White |
| Compatible models | -Hoover "A" Replacement Bags | -Hoover 4010001A Type A Vacuum Bags, 6 Bags | -Hoover 4010001A Type A Vacuum Bags, 9 Bags | Style A10 Pack Hoover Type A Paper Vacuum Bags. Fits Hoover Style A. Replaces Part #4010001A. 2 Ply Micro Filtration | UprightHoover Type A Vacuum Bags (3-Pack), 4010001A | CanisterHoover Vacuum Bags R30 Microfiltration After Market | Type AReplacement Part For Hoover Type A Allergen Bag - 3 pack, 4010100A | CanisterReplacement Part For Hoover Vacuum Bags Style K # 4010028K | 4010001AReplacement Part For Hoover 4010001A Type A Vacuum Bags, 3 Bags | WindTunnelHoover Type Y Allergen Bags, for WindTunnel Vacuum Cleaners, 3-Pack, 4010100Y, White |
About this item
Product details
Fits top fill upright vacuum cleaners: Convertible, Elite, Legacy, Decades, Concept One, Encore, Power Max, Runabout, Spectrum, Spirit, Sprint, Tempo, and Conquest. Also fits Innovation Cleaners.
Hoover Allergen Filtration Vacuum Cleaner Bag :
- Traps 100% of dust mites and their eggs.
- Retains 99.9% of ragweed and common grass pollens.
- Filters a wide range of airborne particles including many pollens, cat dander, spores, and other allergens.
- Electrostatically charged liner enhances the capture of fine particles.
- Ideal for many with allergic or dust related discomforts
Specifications
Compatibility
Compatible models
Hoover Upright Vacuum Cleaners
- C1632 Nla Professional
- C1515 Commercial
Brand
Vacuum cleaner bag type
Directions
Instructions
Warranty
Warranty information
Please be aware that the warranty terms on items offered for sale by third party Marketplace sellers may differ from those displayed in this section (if any). To confirm warranty terms on an item offered for sale by a third party Marketplace seller, please use the 'Contact seller' feature on the third party Marketplace seller's information page and request the item's warranty terms prior to purchase.
Similar items you might like
Based on what customers bought
Hoover 4010100Z Type Z Allergen Vacuum Bags, 3 Count $12.52 96.7 ¢/ft
 Sponsored$1252current price $12.5296.7 ¢/ft
Sponsored$1252current price $12.5296.7 ¢/ftHoover 4010100Z Type Z Allergen Vacuum Bags, 3 Count
144.1 out of 5 Stars. 14 reviewsShipping, arrives in 3+ days10 Pack Hoover Type A Paper Vacuum Bags. Fits Hoover Style A. Replaces Part #4010001A. 2 Ply Micro Filtration $14.95
 Sponsored$1495current price $14.95
Sponsored$1495current price $14.9510 Pack Hoover Type A Paper Vacuum Bags. Fits Hoover Style A. Replaces Part #4010001A. 2 Ply Micro Filtration
185 out of 5 Stars. 18 reviewsShipping, arrives in 3+ daysHoover 4010001A Type A Vacuum Bags, 6 Bags $13.95 $2.33/ea
 $1395current price $13.95$2.33/ea
$1395current price $13.95$2.33/eaHoover 4010001A Type A Vacuum Bags, 6 Bags
944.4 out of 5 Stars. 94 reviewsShipping, arrives in 3+ daysHoover 4010001A Type A Vacuum Bags, 9 Bags $13.49 Was $15.40
 Now$1349current price Now $13.49, Was $15.40$15.40
Now$1349current price Now $13.49, Was $15.40$15.40Hoover 4010001A Type A Vacuum Bags, 9 Bags
394.1 out of 5 Stars. 39 reviewsShipping, arrives in 3+ daysReplacement Part For Hoover Type A Vacuum Cleaner Bags $9.56
 $956current price $9.56
$956current price $9.56Replacement Part For Hoover Type A Vacuum Cleaner Bags
164.9 out of 5 Stars. 16 reviewsShipping, arrives in 3+ daysHoover Conquest Vacuum Type-A Allergen Bags $31.85
 $3185current price $31.85
$3185current price $31.85Hoover Conquest Vacuum Type-A Allergen Bags
214.5 out of 5 Stars. 21 reviewsShipping, arrives in 3+ daysBest seller Great Value Hoover Style A Vacuum Bag, 3-Pack, 2332 $10.58
Best seller 2 optionsAvailable in additional 2 options$1058current price $10.58Options from $10.58 – $31.74
2 optionsAvailable in additional 2 options$1058current price $10.58Options from $10.58 – $31.74Great Value Hoover Style A Vacuum Bag, 3-Pack, 2332
894.5 out of 5 Stars. 89 reviewsSave withPickup todayDelivery todayShipping, arrives todayGenuine Hoover Type A Vacuum Cleaner Bags Style 4010001 4010324 43655010 OEM Vac [2 Loose Bags] $8.27
![Genuine Hoover Type A Vacuum Cleaner Bags Style 4010001 4010324 43655010 OEM Vac [2 Loose Bags]](https://i5.walmartimages.com/asr/ef41ad55-2167-4f2c-9a67-c230c48bbb48.a4668a4fb6a4eac79479a159e41d5cca.jpeg?odnHeight=576&odnWidth=576&odnBg=FFFFFF) $827current price $8.27
$827current price $8.27Genuine Hoover Type A Vacuum Cleaner Bags Style 4010001 4010324 43655010 OEM Vac [2 Loose Bags]
Shipping, arrives in 3+ daysHoover Type A Vacuum Bags (3-Pack), 4010001A $9.95
 $995current price $9.95
$995current price $9.95Hoover Type A Vacuum Bags (3-Pack), 4010001A
674.5 out of 5 Stars. 67 reviewsShipping, arrives in 3+ daysHoover - Bag - for vacuum cleaner $17.69
 $1769current price $17.69
$1769current price $17.69Hoover - Bag - for vacuum cleaner
Shipping, arrives in 3+ daysReplacement Part For Hoover Type A Allergen Bag - 3 pack, 4010100A $11.93
 $1193current price $11.93
$1193current price $11.93Replacement Part For Hoover Type A Allergen Bag - 3 pack, 4010100A
34.3 out of 5 Stars. 3 reviewsShipping, arrives in 3+ daysReplacement Part For Hoover Vacuum Bags Style K # 4010028K $3.87 Was $9.16
 Now$387current price Now $3.87, Was $9.16$9.16
Now$387current price Now $3.87, Was $9.16$9.16Replacement Part For Hoover Vacuum Bags Style K # 4010028K
54.8 out of 5 Stars. 5 reviewsShipping, arrives in 3+ daysReplacement Part For Hoover 4010001A Type A Vacuum Bags, 3 Bags $9.56
 $956current price $9.56
$956current price $9.56Replacement Part For Hoover 4010001A Type A Vacuum Bags, 3 Bags
24.5 out of 5 Stars. 2 reviewsShipping, arrives in 3+ daysVacBagsUSA® Replacement Paper Vacuum Cleaner Bags For Hoover* Type R $8.73
 2 optionsAvailable in additional 2 options$873current price $8.73Options from $8.73 – $11.53
2 optionsAvailable in additional 2 options$873current price $8.73Options from $8.73 – $11.53VacBagsUSA® Replacement Paper Vacuum Cleaner Bags For Hoover* Type R
Shipping, arrives in 3+ daysHoover Type Y Allergen Bags, for WindTunnel Vacuum Cleaners, 3-Pack, 4010100Y, White $14.93
 $1493current price $14.93
$1493current price $14.93Hoover Type Y Allergen Bags, for WindTunnel Vacuum Cleaners, 3-Pack, 4010100Y, White
254.8 out of 5 Stars. 25 reviewsShipping, arrives in 3+ daysReplacement Part For Hoover 6 Allergy Vacuum Type a Bags, Convertible, Elite, Legacy, Decades, Concept One, Encore, PowerMax, Runabout, Spect $10.96
 $1096current price $10.96
$1096current price $10.96Replacement Part For Hoover 6 Allergy Vacuum Type a Bags, Convertible, Elite, Legacy, Decades, Concept One, Encore, PowerMax, Runabout, Spect
95 out of 5 Stars. 9 reviewsShipping, arrives in 3+ daysVacBagsUSA® Replacement Paper Vacuum Cleaner Bags For Hoover* Type K $8.31
 2 optionsAvailable in additional 2 options$831current price $8.31Options from $8.31 – $14.53
2 optionsAvailable in additional 2 options$831current price $8.31Options from $8.31 – $14.53VacBagsUSA® Replacement Paper Vacuum Cleaner Bags For Hoover* Type K
Shipping, arrives in 3+ daysReplacement Part For Hoover Type K Bag (3-Pack), 4010028K $9.79
 $979current price $9.79
$979current price $9.79Replacement Part For Hoover Type K Bag (3-Pack), 4010028K
184.4 out of 5 Stars. 18 reviewsShipping, arrives in 3+ daysReplacement Part For Hoover 4010001A Type A Vacuum Bags, 6 Bags $13.76
 $1376current price $13.76
$1376current price $13.76Replacement Part For Hoover 4010001A Type A Vacuum Bags, 6 Bags
Shipping, arrives in 3+ days
Popular items in this category
Best selling items that customers love
Best seller 15 Pack Style 7 Vacuum Cleaner Bags Replacement for Bissell PowerForce Upright Vacuums 1739 3522 3525 3545 3550 3554 6592 Series, Replace Part # 32120 $17.89
Best seller Sponsored$1789current price $17.89
Sponsored$1789current price $17.8915 Pack Style 7 Vacuum Cleaner Bags Replacement for Bissell PowerForce Upright Vacuums 1739 3522 3525 3545 3550 3554 6592 Series, Replace Part # 32120
374.6 out of 5 Stars. 37 reviewsSave withShipping, arrives tomorrowGuerkuk VRC2 Cloth Filter Bags for Vacmaster 1.5 to 3.2 Gallon Vacuums, 6-Pack $13.99
 Sponsored$1399current price $13.99
Sponsored$1399current price $13.99Guerkuk VRC2 Cloth Filter Bags for Vacmaster 1.5 to 3.2 Gallon Vacuums, 6-Pack
15 out of 5 Stars. 1 reviewsSave withShipping, arrives tomorrow1024039 CANISTER COLLCTN BAG Replacement part for Oreck Canister Vacuum Bags Bag (Pack of 1) $18.38
 $1838current price $18.38
$1838current price $18.381024039 CANISTER COLLCTN BAG Replacement part for Oreck Canister Vacuum Bags Bag (Pack of 1)
94.7 out of 5 Stars. 9 reviewsShipping, arrives in 3+ daysXL8000/9000/2000 Oreck Vacuum Cleaner Replacement Bag (9 Pack) $24.99
 $2499current price $24.99
$2499current price $24.99XL8000/9000/2000 Oreck Vacuum Cleaner Replacement Bag (9 Pack)
413.8 out of 5 Stars. 41 reviewsShipping, arrives in 3+ daysBissell Zing Canister Vacuum Bags, 3 Pack, 2138425 $13.06 Was $24.07
 Now$1306current price Now $13.06, Was $24.07$24.07
Now$1306current price Now $13.06, Was $24.07$24.07Bissell Zing Canister Vacuum Bags, 3 Pack, 2138425
114.3 out of 5 Stars. 11 reviewsShipping, arrives in 3+ daysBagless Canister Vacuum Cleaner Replacement filter For Eureka for NEN180 Parts $4.29
 $429current price $4.29+$4.99 shipping
$429current price $4.29+$4.99 shippingBagless Canister Vacuum Cleaner Replacement filter For Eureka for NEN180 Parts
Shipping, arrives in 3+ daysNutone 391 Replacement Bags for Central Vac, Set of 3 Six Gallon Bags $18.49
 $1849current price $18.49
$1849current price $18.49Nutone 391 Replacement Bags for Central Vac, Set of 3 Six Gallon Bags
214.8 out of 5 Stars. 21 reviewsShipping, arrives in 3+ daysShop-Vac 5-8 Gallon Disposable Filter Bags, 5 Pack $15.99
 $1599current price $15.99
$1599current price $15.99Shop-Vac 5-8 Gallon Disposable Filter Bags, 5 Pack
Shipping, arrives in 3+ daysShop-Vac 10-14 Gallon Disposable Filter Bags, 5 Pack $21.99
 $2199current price $21.99
$2199current price $21.99Shop-Vac 10-14 Gallon Disposable Filter Bags, 5 Pack
Shipping, arrives in 3+ daysBest seller 10 Pack Style 7 Vacuum Cleaner Bags Replacement for Bissell PowerForce Upright Vacuums 1739 3522 3525 3545 3550 3554 6592 Series $13.99
Best seller $1399current price $13.99
$1399current price $13.9910 Pack Style 7 Vacuum Cleaner Bags Replacement for Bissell PowerForce Upright Vacuums 1739 3522 3525 3545 3550 3554 6592 Series
434.7 out of 5 Stars. 43 reviewsSave withShipping, arrives tomorrowReplacement Bissell Style 7 Bags (6 Pack) $12.95
 $1295current price $12.95
$1295current price $12.95Replacement Bissell Style 7 Bags (6 Pack)
534.7 out of 5 Stars. 53 reviewsShipping, arrives in 3+ daysReplacement Belt for Elite Rewind Bagless Upright Vacuum Cleaner, 2/Pack $8.49 Was $11.49
 Now$849current price Now $8.49, Was $11.49$11.49
Now$849current price Now $8.49, Was $11.49$11.49Replacement Belt for Elite Rewind Bagless Upright Vacuum Cleaner, 2/Pack
1534.4 out of 5 Stars. 153 reviewsShipping, arrives in 3+ daysHoover Type I HEPA Bag (4 Bags) AH10005 $16.53
 $1653current price $16.53
$1653current price $16.53Hoover Type I HEPA Bag (4 Bags) AH10005
394.5 out of 5 Stars. 39 reviewsShipping, arrives in 3+ daysReplacement Part For Bissell Vacuum PowerForce Brush Roller 203-1289, 2038072 $9.83 Was $16.43
 Now$983current price Now $9.83, Was $16.43$16.43
Now$983current price Now $9.83, Was $16.43$16.43Replacement Part For Bissell Vacuum PowerForce Brush Roller 203-1289, 2038072
112.5 out of 5 Stars. 11 reviewsShipping, arrives in 3+ daysOreck Belt, Upright Flat (Pack of 3) $8.09
 $809current price $8.09
$809current price $8.09Oreck Belt, Upright Flat (Pack of 3)
115 out of 5 Stars. 11 reviewsShipping, arrives in 3+ daysBest seller BISSELL Style 7 Vacuum Bags for Bagged Vacuums, 3 pk, 32120 $7.98
Best seller $798current price $7.98
$798current price $7.98BISSELL Style 7 Vacuum Bags for Bagged Vacuums, 3 pk, 32120
2234.8 out of 5 Stars. 223 reviewsSave withShipping, arrives tomorrowElectrolux Home Products 1024259 Clsic Paper Vacum Bag, Pack of 5 $12.40 43.9 ¢/ea
 $1240current price $12.4043.9 ¢/ea
$1240current price $12.4043.9 ¢/eaElectrolux Home Products 1024259 Clsic Paper Vacum Bag, Pack of 5
223.7 out of 5 Stars. 22 reviewsShipping, arrives in 3+ daysEureka Canister Vacuum Cleaner Floor Tool Attachment $17.54 $17.54/count
 $1754current price $17.54$17.54/count
$1754current price $17.54$17.54/countEureka Canister Vacuum Cleaner Floor Tool Attachment
33.7 out of 5 Stars. 3 reviewsShipping, arrives in 3+ daysReplacement Part For Hoover FH52000 Vacuum Cleaner Carpet Washer Hose # 440012815 $65.75
 $6575current price $65.75
$6575current price $65.75Replacement Part For Hoover FH52000 Vacuum Cleaner Carpet Washer Hose # 440012815
24 out of 5 Stars. 2 reviewsShipping, arrives in 3+ daysTop Vacuum Parts Vacuum Cleaner Filters for Bissell (1 Pack) $11.53 Was $13.92
 Now$1153current price Now $11.53, Was $13.92$13.92
Now$1153current price Now $11.53, Was $13.92$13.92Top Vacuum Parts Vacuum Cleaner Filters for Bissell (1 Pack)
144.1 out of 5 Stars. 14 reviewsShipping, arrives in 3+ days
Check out these related products
Hoover Type A Allergen Bag - 9 Bags 4010100A $39.95
 $3995current price $39.95
$3995current price $39.95Hoover Type A Allergen Bag - 9 Bags 4010100A
Shipping, arrives in 3+ daysEnvirocare Kenmore Mircrofiltration Canister Vacuum Bags - 50558, 5055, 50557 9pk (9 Bags & 1 EF2 Filter) $13.95
 $1395current price $13.95
$1395current price $13.95Envirocare Kenmore Mircrofiltration Canister Vacuum Bags - 50558, 5055, 50557 9pk (9 Bags & 1 EF2 Filter)
94.1 out of 5 Stars. 9 reviewsShipping, arrives in 3+ daysEnviroCare Compatible with Kenmore Micro Filtration Canister Vacuum bags, 9 pack $13.75
 $1375current price $13.75
$1375current price $13.75EnviroCare Compatible with Kenmore Micro Filtration Canister Vacuum bags, 9 pack
Shipping, arrives in 3+ daysEnviroCare Replacement Vacuum Bags Designed to Fit Kenmore Canister Type C or Q 50555, 50558, 50557 and Panasonic Type C-5 18 pack $20.26
 $2026current price $20.26
$2026current price $20.26EnviroCare Replacement Vacuum Bags Designed to Fit Kenmore Canister Type C or Q 50555, 50558, 50557 and Panasonic Type C-5 18 pack
35 out of 5 Stars. 3 reviewsShipping, arrives in 3+ daysCompatible with Kirby G4 & G5 Vacuum Cleaner Bags #197394A - 9 Pack $22.17
 $2217current price $22.17
$2217current price $22.17Compatible with Kirby G4 & G5 Vacuum Cleaner Bags #197394A - 9 Pack
604.7 out of 5 Stars. 60 reviewsShipping, arrives in 3+ daysRoyal-AR10140 Royal Aire Filtration Vacuum Bags, Type-Y, 7 Pack $20.37
 $2037current price $20.37
$2037current price $20.37Royal-AR10140 Royal Aire Filtration Vacuum Bags, Type-Y, 7 Pack
74.4 out of 5 Stars. 7 reviewsShipping, arrives in 3+ daysReplacement Part For Hoover Type S Allergen Back, 4010100S (9 Pack) $18.22
 $1822current price $18.22
$1822current price $18.22Replacement Part For Hoover Type S Allergen Back, 4010100S (9 Pack)
Shipping, arrives in 3+ daysCompatible with Oreck Type CC HEPA Upright Vacuum Cleaner Bag, AK1CC6H, 6-Pack, 6 Pack, Purple, 6 Count $28.66
$2866current price $28.66
$2866current price $28.66Compatible with Oreck Type CC HEPA Upright Vacuum Cleaner Bag, AK1CC6H, 6-Pack, 6 Pack, Purple, 6 Count
62.3 out of 5 Stars. 6 reviewsShipping, arrives in 3+ days
Customer ratings & reviews
Filtered and sorted results would be available on the new 'Customer ratings & reviews' page.
Showing 1-3 of 26 reviews
Seller Verified Purchase
User Friendly Website for Replacement Bags
I live in Sacamento, California and have found it difficult to find replacement bags for my Hoover vacumn. The website was easy to find, locate the item I needed and process the order with a timely and efficient delivery system.
Seller Verified Purchase
The best vacuum company out there!
[This review was collected as part of a promotion.] The produce it great, but the people in customer service are better yet. I needed to order Type A Bags & drive belt. This particular Hoover is over 20 years old. It has taken a licking and still runs like new. I needed to change the drive belt and I could not find my owners manual. The customer service representatives went out of their way to locate a service manual as how to gain access to the drive belt and how to install a new one, plus emailed me a parts manual for this older Hoover. My wife always orders Hoover whenever possible for her cleaning needs, and with a dedicated team of professionals at Hoover customer service she will never change brands. Thank you Hoover, Chic
Seller Verified Purchase
The best vacuum company out there!
[This review was collected as part of a promotion.] The produce it great, but the people in customer service are better yet. I needed to order Type A Bags & drive belt. This particular Hoover is over 20 years old. It has taken a licking and still runs like new. I needed to change the drive belt and I could not find my owners manual. The customer service representatives went out of their way to locate a service manual as how to gain access to the drive belt and how to install a new one, plus emailed me a parts manual for this older Hoover. My wife always orders Hoover whenever possible for her cleaning needs, and with a dedicated team of professionals at Hoover customer service she will never change brands. Thank you Hoover, Chic
Similar items that are easy to use
Based on customer reviews
Replacement Part For Hoover Model UH30010COM Style Q Allergen Filtration Vacuum Bags 3pk & Style I Allergen Filtration Vacuum Bags 3pk # A890 & A891 $14.65
 $1465current price $14.65
$1465current price $14.65Replacement Part For Hoover Model UH30010COM Style Q Allergen Filtration Vacuum Bags 3pk & Style I Allergen Filtration Vacuum Bags 3pk # A890 & A891
724.7 out of 5 Stars. 72 reviewsShipping, arrives in 3+ daysReplacement Part For Hoover Cloth Style Q HEPA Vacuum Bags Type AH10000 UH30010 Platinum Vac [10 Bags] $45.79
![Replacement Part For Hoover Cloth Style Q HEPA Vacuum Bags Type AH10000 UH30010 Platinum Vac [10 Bags]](https://i5.walmartimages.com/asr/ae401e75-062c-4ffd-9333-4b2938c16923.6e9fb9713c5301363ac0dd04d497304b.jpeg?odnHeight=576&odnWidth=576&odnBg=FFFFFF) $4579current price $45.79
$4579current price $45.79Replacement Part For Hoover Cloth Style Q HEPA Vacuum Bags Type AH10000 UH30010 Platinum Vac [10 Bags]
724.7 out of 5 Stars. 72 reviewsShipping, arrives in 3+ daysReplacement Part For Hoover AH10000 Platinum Type-Q & I HEPA Vacuum Bags (2 Q bags & 2 I Bags) // AH10005 & AH10000 $7.71 Was $14.59
 Now$771current price Now $7.71, Was $14.59$14.59
Now$771current price Now $7.71, Was $14.59$14.59Replacement Part For Hoover AH10000 Platinum Type-Q & I HEPA Vacuum Bags (2 Q bags & 2 I Bags) // AH10005 & AH10000
724.7 out of 5 Stars. 72 reviewsShipping, arrives in 3+ daysGenuine Hoover Cloth Style Q HEPA Vacuum Bags Type AH10000 UH30010 Platinum Vac [4 Bags] $23.25
![Genuine Hoover Cloth Style Q HEPA Vacuum Bags Type AH10000 UH30010 Platinum Vac [4 Bags]](https://i5.walmartimages.com/asr/ae401e75-062c-4ffd-9333-4b2938c16923.6e9fb9713c5301363ac0dd04d497304b.jpeg?odnHeight=576&odnWidth=576&odnBg=FFFFFF) $2325current price $23.25
$2325current price $23.25Genuine Hoover Cloth Style Q HEPA Vacuum Bags Type AH10000 UH30010 Platinum Vac [4 Bags]
734.7 out of 5 Stars. 73 reviewsShipping, arrives in 3+ daysReplacement Part For Hoover Cloth Style Q HEPA Vacuum Bags Type AH10000 UH30010 Platinum Vac [20 Bags] $85.77
![Replacement Part For Hoover Cloth Style Q HEPA Vacuum Bags Type AH10000 UH30010 Platinum Vac [20 Bags]](https://i5.walmartimages.com/asr/ae401e75-062c-4ffd-9333-4b2938c16923.6e9fb9713c5301363ac0dd04d497304b.jpeg?odnHeight=576&odnWidth=576&odnBg=FFFFFF) $8577current price $85.77
$8577current price $85.77Replacement Part For Hoover Cloth Style Q HEPA Vacuum Bags Type AH10000 UH30010 Platinum Vac [20 Bags]
724.7 out of 5 Stars. 72 reviewsShipping, arrives in 3+ daysReplacement Part For Hoover AH10000 Platinum Type-Q & I HEPA Vacuum Bags (6 Q bags & 4 I Bags) // AH10005 & AH10000 $40.12
 $4012current price $40.12
$4012current price $40.12Replacement Part For Hoover AH10000 Platinum Type-Q & I HEPA Vacuum Bags (6 Q bags & 4 I Bags) // AH10005 & AH10000
724.7 out of 5 Stars. 72 reviewsShipping, arrives in 3+ daysReplacement Part For Hoover Type Q AH10000 Platinum Upright Vacuum Cleaner HEPA AH10000, 302982002, A890 Bags( 4 Packs of 3: Total 12 Bags )For UH30010COM, UH30010 $39.45
 $3945current price $39.45
$3945current price $39.45Replacement Part For Hoover Type Q AH10000 Platinum Upright Vacuum Cleaner HEPA AH10000, 302982002, A890 Bags( 4 Packs of 3: Total 12 Bags )For UH30010COM, UH30010
724.7 out of 5 Stars. 72 reviewsShipping, arrives in 3+ days
